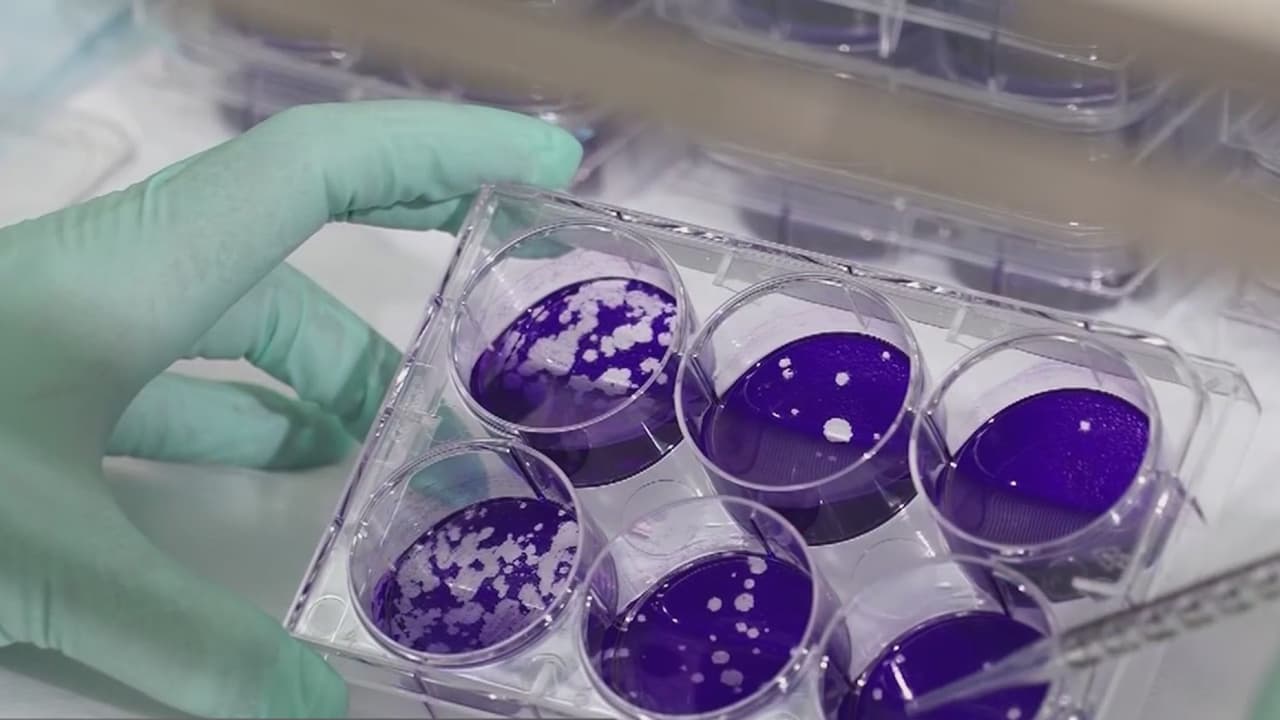

Tres bomberos y dos paramédicos de Scottsdale, Arizona se encuentran bajo protocolo de aislamiento después de estar en contacto con el segundo presunto caso del nuevo coronavirus en el estado.
En aislamiento 3 bomberos y 2 paramédicos de Arizona tras estar en contacto con el segundo posible paciente de coronavirus
Las cinco personas seguirán en distanciamiento social durante 12-14 días. Sin embargo, de acuerdo con las autoridades de salud, no han mostrado ningún síntoma del covid-19.

" El equipo de bomberos y el equipo de ambulancias fueron excluidos del trabajo como medida de precaución y seguirán las pautas de distanciamiento social durante 12-14 días por dirección del Departamento de Salud Pública del condado de Maricopa", se lee en un comunicado.
Desde entonces, solo un bombero (inicialmente eran cuatro) recibió autorización para regresar a trabajar. Los otros todavía están bajo protocolo de aislamiento, pero no han mostrado ningún síntoma del covid-19.
“Los servicios de emergencias médicas y las instituciones de atención médica están capacitados y equipados para responder a enfermedades infecciosas. Debido a que el personal involucrado siguió prácticas y procedimientos estándar para limitar la exposición a contagios, no hay motivo de preocupación entre ninguna otra persona a la que posteriormente hayan cuidado", explica el condado de Maricopa.
El Departamento de Salud Pública del condado informó que cuando se tienen sospechas, entrevistan al paciente, evalúan sus circunstancias particulares y determinan a cualquier otra persona que pueda estar en riesgo. Luego se contacta a esas personas y se les brinda orientación sobre lo que deben hacer.
¿El segundo caso de covid-19 en Arizona?
Los funcionarios de salud no han ofrecido mucha información sobre el segundo posible caso de coronavirus en Arizona. Los funcionarios de salud del condado de Maricopa confirmaron el martes que un hombre de unos 20 años dio, al parecer, "positivo".
Los Centros para el Control y Prevención de Enfermedades definen un caso "presuntamente positivo" de COVID-19 como un caso que ha dado positivo por agencias locales pero que aún no ha sido confirmado por ellos.
Por el momento, del paciente se sabe que fue considerado oficialmente "presunto positivo" el 3 de marzo, ocurrió en el condado de Maricopa, las autoridades describen al individuo como un hombre de unos veinte años, el contacto ocurrió fuera de Arizona y que el hombre está en autoaislamiento.